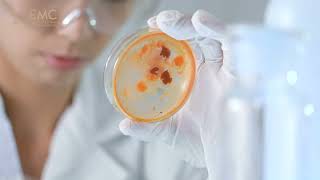

Самое популярное:
-
 КАК ПРОХОДИТ ХИМИОТЕРАПИЯ ПРИ РАКЕ КИШЕЧНИКА
2004
КАК ПРОХОДИТ ХИМИОТЕРАПИЯ ПРИ РАКЕ КИШЕЧНИКА
2004
-
 ИЗ ЧЕГО СОСТОИТ ОПУХОЛЬ
8166
ИЗ ЧЕГО СОСТОИТ ОПУХОЛЬ
8166
-
 ПОЧЕМУ НЕ ВСЕ БОЛЕЮТ ОНКОЛОГИЕЙ
5058
ПОЧЕМУ НЕ ВСЕ БОЛЕЮТ ОНКОЛОГИЕЙ
5058
-
 ПОКРАСНЕНИЕ ВОКРУГ ШВА ПОСЛЕ ЭНДОПРОТЕЗИРОВАНИЯ
9721
ПОКРАСНЕНИЕ ВОКРУГ ШВА ПОСЛЕ ЭНДОПРОТЕЗИРОВАНИЯ
9721
-
 МОЖНО ЛИ ЯБЛОЧНЫМ УКСУСОМ ПРОТИРАТЬ ЛИЦО
5723
МОЖНО ЛИ ЯБЛОЧНЫМ УКСУСОМ ПРОТИРАТЬ ЛИЦО
5723
-
 МАТОЧНОЕ МОЛОЧКО ПРИ ОНКОЛОГИИ
8186
МАТОЧНОЕ МОЛОЧКО ПРИ ОНКОЛОГИИ
8186
-
 КАК ВЫГЛЯДИТ ДОБРОКАЧЕСТВЕННАЯ ОПУХОЛЬ НА УЗИ
4410
КАК ВЫГЛЯДИТ ДОБРОКАЧЕСТВЕННАЯ ОПУХОЛЬ НА УЗИ
4410
-
 ПОМОГАЕТ ЛИ РЕТИНОЕВАЯ МАЗЬ ОТ МОРЩИН
2672
ПОМОГАЕТ ЛИ РЕТИНОЕВАЯ МАЗЬ ОТ МОРЩИН
2672
-
 ТАБЛЕТКИ ОТ БЕСПЛОДИЯ ДЛЯ ЖЕНЩИН И ПРЕПАРАТЫ ЛЕЧЕНИЕ
9977
ТАБЛЕТКИ ОТ БЕСПЛОДИЯ ДЛЯ ЖЕНЩИН И ПРЕПАРАТЫ ЛЕЧЕНИЕ
9977
Реклама